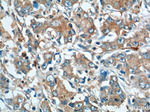
URG4 Antibody in Immunohistochemistry (Paraffin) (IHC (P))
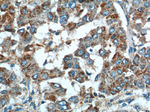
URG4 Antibody in Immunohistochemistry (Paraffin) (IHC (P))
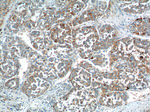
URG4 Antibody in Immunohistochemistry (Paraffin) (IHC (P))

Search
Proteintech
URG4 Polyclonal Antibody
{{$productOrderCtrl.translations['antibody.pdp.commerceCard.promotion.promotions']}}
{{$productOrderCtrl.translations['antibody.pdp.commerceCard.promotion.viewpromo']}}
{{$productOrderCtrl.translations['antibody.pdp.commerceCard.promotion.promocode']}}: {{promo.promoCode}} {{promo.promoTitle}} {{promo.promoDescription}}. {{$productOrderCtrl.translations['antibody.pdp.commerceCard.promotion.learnmore']}}
产品信息
11998-1-AP
种属反应
宿主/亚型
分类
类型
抗原
偶联物
形式
浓度
规格
纯化类型
保存液
内含物
保存条件
运输条件
产品详细信息
Immunogen sequence: MASPGHSDL GEVAPEIKAS ERRTAVAIAD LEWREMEGDD CEFRYGDGTN EAQDNDFPTV ERSRLQEMLS LLGLETYQVQ KLSLQDSLQI SFDSMKNWAP QVPKDLPWNF LRKLQALNAD ARNTTMVLDV LPDARPVEKE SQMEEEIIYW DPADDLAADI YSFSELPTPD TPVNPLDLLC ALLLSSDSFL QQEIALKMAL CQFALPLVLP DSENHYHTFL LWAMRGIVRT WWSQPPRGMG SFREDSVVLS RAPAFAFVRM DVSSNSKSQL LNAVLSPGHR QWDCFWHRDL NLGTNAREIS DGLVEISWFF PSGREDLDIF PEPVAFLNLR GDIGSHWLQF KLLTEISSAV FILTDNISK (1-358 aa encoded by BC018426 )
靶标信息
The specific function of this protein remains unknown. URG4 is upregulated in the presence of hepatitis B virus (HBV)-encoded X antigen (HBxAg) and may contribute to the development of hepatocellular carcinoma by promoting hepatocellular growth and survival (Tufan et al., 2002 ).
仅用于科研。不用于诊断过程。未经明确授权不得转售。
生物信息学
蛋白别名: DKFZp666G166; DKFZp686O0457; HBV X protein up-regulated gene 4 protein; HBxAg up-regulated gene 4 protein; oncoprotein; unnamed protein product; up-regulated gene 4; Up-regulator of cell proliferation
基因别名: KIAA1507; URG4; URGCP
UniProt ID: (Human) Q8TCY9
Entrez Gene ID: (Human) 55665